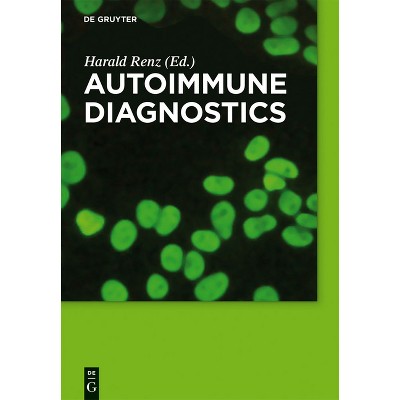

understanding pathophysiology
Sponsored
$44.95 - $159.95
MSRP $54.95 - $179.95
Sponsored
Related searches
- obesity pathophysiology
- understanding biostatistics
- understanding human development
- understanding nft
- understanding the power of the mind
- understanding molecular simulation
- understanding social welfare 9th edition
- understanding reality television
- understanding the power of vision
- understanding symbolic logic
- understanding economic indicators
- understanding motor controls 2nd edition
- understanding operating systems 6th edition
- understanding human behavior and the social environment
- understanding applied behavior analysis
- break up proof
- catholic converts
- amanda quick
- interfacial electrochemistry
- voices are not for yelling